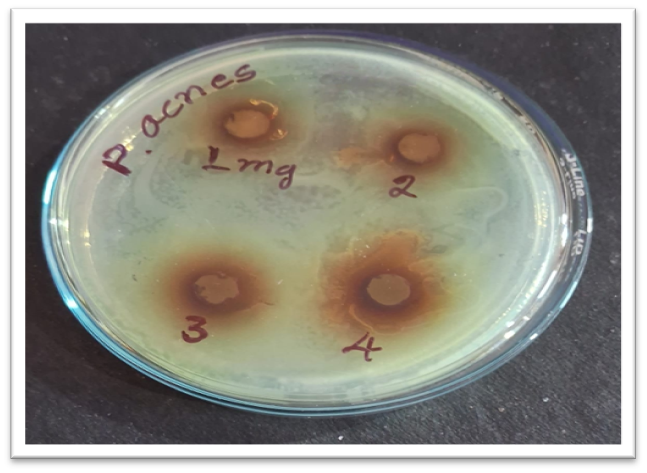

We use cookies to ensure our website works properly and to personalise your experience. Cookies policy

We use cookies to ensure our website works properly and to personalise your experience. Cookies policy
Department of Pharmaceutics, Rani Chennamma College of Pharmacy, Belagavi-10, Karnataka, India
Acne vulgaris is a prevalent chronic inflammatory disorder of the pilosebaceous unit that affects a significant proportion of the population, particularly adolescents and young adults. Its pathogenesis involves excessive sebum production, follicular hyperkeratinization, inflammation, and colonization by Propionibacterium acnes. The long-term use of synthetic anti-acne agents is often associated with adverse effects, prompting increased interest in herbal-based alternatives. In the present study, a polyherbal anti-acne cream was formulated using extracts of Ocimum sanctum (Tulsi), Azadirachta indica (Neem), and Triphala. The plant materials were extracted by the maceration method using ethanol as the solvent. Phytochemical screening confirmed the presence of bioactive constituents including alkaloids, flavonoids, glycosides, tannins, carbohydrates, and proteins. Two formulations (F1 and F2) were developed using the trituration method with beeswax, liquid paraffin, borax, methyl paraben, distilled water, and rose oil. Both formulations were evaluated for physicochemical and functional parameters such as organoleptic properties, pH, viscosity, spreadability, washability, phase separation, minimum inhibitory concentration (MIC), and zone of inhibition (ZOI). The formulations exhibited acceptable physicochemical characteristics and good stability. Notably, both F1 and F2 demonstrated significant antimicrobial activity against P. acnes. The findings suggest that the developed polyherbal cream is stable, safe, and effective, highlighting its potential as a natural therapeutic alternative for the management of acne vulgaris.
Many people prefer the herbal product over the synthetic one, synthetic product produce several harmful side effects as compared to the herbal product have minimal side effect.[1]
Herbal cosmetics are defined as the beauty products which posses desirable physiological activity such as healing, smoothing, appearance, enhancing and conditioning properties of herbal ingredients. Nowadays there is great demand for the herbal cosmetics.[2]
The word “cosmetic” derived from a Greek word “kosmesticos” that means to adorn.[3]
TOPICAL DRUG DELIVERY
Over the last decades the treatment of illness have been accomplished by administrating drugs to human body via various routes namely oral, sublingual, rectal, parental, topical, inhalation. Topical delivery can be defined as the application of a drug containing formulation to the skin to directly treat cutaneous disorder or the cutaneous manifestations of a general disease with the intent of containing pharmacological or the effect of drug to the surface of the skin or within the skin semisolid formulations in all their diversity dominate the system for topical delivery.
Advantages of topical drug delivery system:
ANATOMY OF SKIN
In concern of weight and surface area, the skin is the largest organ in the body. Its surface area is around 16,000cm2. Skin contributes to 8% of adult body weight. It is the live body’s outermost layer or tissue. Skin behaves as a defense against the external environment. When disclose to sunshine, skin can generate a beneficial chemical compound known as Vit-D. The skin serves as a sensory organ and assists in controlling body temperature. Skin has a various types of biological components, including keratinocytes, melanocytes and erythrocytes. As a result of many components like cells and fibers, it exhibits multilayered structures. The skin consists of following skin layers.

The epidermis which has thickness of around 0.2mm. There are no veins and capillaries present in this layer. The thickness of epidermis varies on the location of the body. There are mainly 2 types of cells- keratinocytes and dendritic cells. It accommodates additional cells like melanocytes, Langerhans cells etc. Epidermis is also labeled as metabolic active tissues.
The outermost layer is categorized into 5 sub layers
Most of the dermis is made up of collagen and elastin as well as fibroblasts.
Its thickness is around 1-4mm. The dermis layer consists of two sublayers: papillary and reticular.
The deepest layer of the skin is the layer of fat that connects your bones to muscles. Its thickness is about 4-9mm. It goes so deep that the active ingredients in your skincare products can never reach. The subcutaneous layer is like a thermostat. It protects the body and can also be used as a source of energy in a pinch. Fat also acts as a filter, protecting your muscles, bones and organs from damage. Finally the subcutaneous layer contains additional blood vessels, nerve endings, hair follicular roots and the deepest oil – producing sebaceous glands. [4]
ACNE
The term Acne is derived from Greek word “Acme” which means “prime of life”. Acne is a skin disorder that leads to an outbreak of lesions called pimples or “zits”. Propionibacterium acnes and staphylococcus epidermidis are common pus – forming microbes responsible for the development of various forms of acne. The most common form of disease in adolescents is called acne vulgaris. Patients experience psychological burdens like depression, anxiety and low self- esteem because of acne.The introduction of novel herbal formulations for the treatment of acne may produce many advantages over previously used therapies. These herbal drugs are effective against a variety of Gram-positive and Gram-negative Bacteria. The concerned side effect of herbal drugs are much less compared with modern drugs. Thus, natural substances, which are obtained from the medicinal plant, having antibacterial and anti-inflammatory activity, are commonly employed for treatment of acne.
Types of Acne
CREAM
Cream is defined as semisolid emulsions which are oil in water (o/w) or water in oil (w/o) type and these semisolid emulsions are intended for external applications. Cream is classified as oil in water and water in oil emulsions. It is applied on outer part or superficial part of the skin and its main ability is to remain for a longer period of time at the site of application. The functions of skin cream is to protect the skin against different environmental conditions, weather and gives soothing effect to the skin. There are different types of creams like cleansing, cold, foundation, vanishing, night, massage, hand and body creams.
Advantages of Herbal cream:
AIM
The main aim of our work is to develop an herbal cream which can give multipurpose effect, like moisturizer, reduce acne and skin irritation and also adding glow to the face. We have used three herbal ingredients in our preparation which are Tulsi, Neem, and Triphala.
Tulsi is used to add glow to the skin and to promote wound healing and for antimicrobial property.
Neem is used as an antifungal and anti-inflammatory and it is also used to reduce scar, pigmentation, redness and itching of the skin.
Triphala possesses anti-fungal, anti-inflammatory, antimicrobial and wound healing property.[7][11]
TULSI
Tulsi is an aromatic shrub in the basil family Lamiaceae (tribe ocimeae) that is thought to have originated in north central India and now grows native throughout the eastern world tropics. Within Ayurveda, tulsi is known as “The Incompatible One”, “Mother Medicine of Nature” and “The Queen of Herbs”, and is revered as an “elixir of life” that is without equal for both its medicinal and spiritual properties.[8]
Tulsi extract shows inhibitory effects against pathogen such as Staphylococcus aureus, Propionibacterium acnes, Pseudomonas aeruginosa, E.coli, Klebsiella pneumoniae, Proteus Mirabilis, Salmonella typhimurium. The Tulsi leaves extract has some quantity of volatile oil which contain phytochemicals such as aldehyde, terpenes (sesquiterpenes, monoterpenes) and phenols and it also contains some quantity of saponins, taninns, glycosides, quinone, phlobatanin, flavonoids(orientin and vicenin), Steroids, coumarin and alkaloids. Tulsi is used in medicines and has various therapeutic properties and many useful phytochemicals which act as antimicrobial agents against pathogenic microbes.[9]
NEEM
Neem is a tree in the mahogany family Meliacea. Neem extracts are found to be antimicrobial, antifungal, antiviral, antibacterial and antidiabetic. The chemical constituents and phytoconstituents of Neem are biologically active. Compounds may include secondary metabolites like flavonoids, steroids, tannins, terpenoids, saponins in varying concentrations. Azadirachtin, terpenoid is a low toxic compounds. An antimicrobial is an agent, which kills or inhibit the growth of microorganisms. Neem shows antimicrobial activity against some microorganisms.[10]
TRIPHALA
Triphala is a well-known polyherbal formulation from Ayurveda. It is a rasayana Drug in Indian System of Medicine (ISM). Triphala is a mixture of three fruits which is composed of dried fruits of Embelica offincinalis Gaertn (Euphorbiaceae), Terminalia belerica Linn (Combertaceae) and Terminalia chebula (Combertaceae) in equal proportion (1:1:1) as described in Ayurvedic Formulary of India. It is also used as blood purifier that can improve mental faculties and posseses anti-inflammatory, analgesic,hypoglycemic and anti-aging properties. Triphala is claimed to have antiviral and antibacterial effects. Triphala inhibits the growth of Gram positive and Gram negative bacteria. Triphala is rich in Gallic acid, Vitamin -C, ellagic acid, chebulic acid, bellericanin and ß-sitosterol. Triphala Mashi exhibit antimicrobial activity attributed to phenolic compounds and tannins in triphala. Triphala churna has antibacterial activity against various bacterial pathogens.[11]
MATERIALS AND METHODOLOGY
The active ingredients and other excipients which were used in the present study was given in the table 1 along with their source, grade etc.
Table 1 : List of chemicals used with their grade and sources.
|
Serial no. |
Materials |
Supplier |
|
1 |
Tulsi |
Kle Ayurvedic Aushadhalay |
|
2 |
Neem |
Kle Ayurvedic Aushadhalay |
|
3 |
Triphala |
Kle Ayurvedic Aushadhalay |
|
4 |
Bees wax |
RCCP |
|
5 |
Borax |
RCCP |
|
6 |
Methyl paraben |
RCCP |
|
7 |
Glycerin |
RCCP |
|
8 |
Rose oil |
RCCP |
Extraction of plant materials using cold maceration method:-
Tulsi:-[12]

FIGURE 1: MACERATION OF TULSI
Neem:- [13]

FIGURE 2: MACERATION OF NEEM
Triphala:-[14]

FIGURE 3: MACERATION OF TRIPHALA
Preliminary phytochemical screening
PREPARATION OF ANTI ACNE CREAM

FIGURE 4: FLOWCHART FOR PREPARATION OF CREAM
Table no.2 Formulation of polyherbal anti acne cream
|
Sr . No |
Ingredients |
F1 |
F2 |
Category |
|
1 |
Neem extract |
1g |
1g |
API |
|
2 |
Tulsi extract |
1g |
1g |
API |
|
3 |
Triphala extract |
1g |
1g |
API |
|
4 |
Bees wax |
3g |
4g |
Emulsifying agent |
|
5 |
Liquid paraffin |
10g |
10g |
Soothing agent |
|
6 |
Borax |
0.2g |
0.2g |
Emulsifying agent |
|
7 |
Glycerine |
1g |
1g |
Moisturizer |
|
8 |
Methyl paraben |
0.02g |
0.03g |
Preservative |
|
9 |
Rose oil |
q.s |
q.s |
Fragrance |
|
10 |
Distilled water |
5.61g |
5.61g |
Vehicle |

FIGURE 5: Formulation 1 & 2
POST FORMULATION STUDIES:-[1][14]
Evaluation parameter
1) Physical evaluation:-
The physical parameters of cream like color, odor, consistency, and state of formulations analyzed.
2) Washability:-
On the hand, a little amount of cream was applied and washed it with tap water.
Generally, this test is checked every 24 to 30 hours. Put the cream into the container at room temperature and protect the formulation from the light for this.
The pH of the cream was determined using digital pH meter. The readings were taken for average of 3 times.
Spreadability of formulations was determined by an apparatus suggested by Multimer et al.which was fabricated in laboratory and used for study.
Procedure: An excess of cream sample 2.5g was placed between two glass slides and a 1000g weight was placed on slides for 5 minutes to compress the sample to a uniform thickness. weight (60g) was added to pan. The time (seconds) required to separate the two slides was taken as a measure of spreadability.
It was calculated using the formula
S = m.l / t
Where s – spreadability in g.cm / sec
m- weight tied on upper side(60g)
l – length of glass slideMG
t – time in seconds
6) Viscosity:-
Viscosity of the cream was measured by using Brookfield viscometer. DVII model with a T-bar spindle in combination with a helipath stand T 95 was used for the measurement of viscosity of all gels. The viscosity was measured using 50 gm of cream filled in 100 ml beaker. The T-bar spindle (T 95) was lowered perpendicular in the center taking care that spindle does not touch the bottom of jar.
Measurement of viscosity
The T-bar spindle (T95) was used for determining the viscosity of the creams. The factors like temperature, pressure and sample size etc. which affect the viscosity was maintained constant during the process. The helipath T-bar spindle was moved up and down giving viscosities at number of points along the path. The torque reading was always greater than 10%. The average of three readings taken in one minute was noted as the viscosity of creams.
7) Anti-microbial study of extracts:-
A) Determination of MIC:
B) Zone of inhibition:
Agar well diffusion method:
RESULTSAND DISCUSSION:
PREFORMULATION STUDIES:
Extraction: Tulsi, Neem, and Triphala all have good ability to extract solvent in ethanol. Maceration process gives better yield in all three plants used.
Phytochemical screening: Table 3 represents a phytochemical screening of the ethanolic extract of Tulsi, Neem and Triphala.
Table no.3 Results of phytochemical screening of drug extracts
|
Sr. No. |
Phytoconstituents |
Name of test |
Tulsi |
Neem |
Triphala |
|
1 |
Carbohydrates |
Molisch test |
+ |
+ |
- |
|
Fehling’s test |
+ |
+ |
- |
||
|
2 |
Alkaloids |
Dragendorff’s test |
+ |
+ |
+ |
|
Wagner’s test |
+ |
+ |
+ |
||
|
3 |
Flavonoids |
Shinoda test |
+ |
+ |
+ |
|
Lead acetate test |
+ |
+ |
+ |
||
|
4 |
Glycosides |
Keller killani test |
+ |
+ |
+ |
|
Borntragers test |
+ |
+ |
+ |
||
|
5 |
Tannins |
Gelatin test |
+ |
+ |
+ |
|
5% FeCl3 test |
+ |
+ |
+ |
||
|
6 |
Proteins |
Millon’s test |
- |
- |
+ |
|
Lead acetate test |
- |
- |
+ |
PHYTOCHEMICAL SCREENING OF TULSI

FIGURE 6: PHYTOCHEMICAL SCREENING OF TULSI
PHYTOCHEMICAL SCREENING OF NEEM

FIGURE 7: PHYTOCHEMICAL SCREENING OF NEEM
PHYTOCHEMICAL SCREENING OF TRIPHALA

FIGURE 8: PHYTOCHEMICAL SCREENING OF TRIPHALA
POST FORMUION STUDIES:
Table no.4 Results of evaluation parameters of anti acne cream
|
Sr.no |
Evaluation test |
Formulation 1[F1] |
Formulation 2[F2] |
|
|
1 |
Physical evaluation |
|
|
|
|
|
color |
Tea green |
Tea green |
|
|
|
Texture |
Smooth |
Smooth |
|
|
|
State |
Semi solid |
Semi solid |
|
|
2 |
Washability |
Easily washable |
Easily washable |
|
|
3 |
Phase separation |
No phase separation |
No phase separation |
|
|
4 |
pH |
6 |
7 |
|
|
5 |
Spreadabilty(g/sec) |
35 |
40 |
|
|
6 |
Viscosity(cps) |
21020 |
11810 |
|
|
7 |
Anti- microbial test
|
MIC = 600µg |
||
|
ZOI |
3mg |
8.11mm |
||
|
4mg |
11.44mm |
|||
Table no.5 Results of pH
|
Formulation |
pH reading |
|
F1 |
6 |
|
F2 |
7 |


FIGURE 9: Formulation 1 Formulation
5 ) Spreadability :
Table no.6 Results of spreadability
|
Formulation |
Reading (gm/sec) |
|
F1 |
35 |
|
F2 |
40 |


FIGURE 10: Formulation 1 Formulation 2
6)Viscosity:
Table no.7 Results of viscosity
|
Formulation |
Reading(cps) |
|
F1 |
21020 |
|
F2 |
11810 |


FIGURE 11: Formulation 1 Formulation 2
7) Anti-microbial test :

FIGURE 21: MIC test of sample
FIGURE 22: Zone of inhibition of test sample.
SUMMARY
Polyherbal anti acne cream containing natural ingredients was developed and evaluated using various parameters. Tulsi, Neem& Triphala were extracted by ethanol using maceration method.
These extracts were characterized by various chemical tests like test for alkaloids, carbohydrates, flavonoids, glycosides, tannins, proteins etc. Further, the anti acne cream was prepared by using other ingredients such as bees wax, borax, liquid paraffin, methyl paraben, glycerin, rose oil and distilled water.
The developed formulation was evaluated for parameters like pH, spreadability, washability, viscosity, phase separation, irritancy, and anti –microbial activity, the results obtained of the developed cream was found to be satisfactory.
CONCLUSION:
We made a prompt attempt to develop polyherbal anti acne cream containing Tulsi, Neem, Triphala. The cream was evaluated for various physical and microbiological evaluations.
From the result it was concluded that the anti acne cream was found to be effective against P.acne.
ACKNOWLEDGEMENT
The authors would like to thank KRET’s Rani Chennamma College of Pharmacy,Belagavi,for providing necessary facilities and support for this research work.We would also like to acknowledge Kle Ayurvedic Aushadhalay for providing the materials for this research work.
REFERENCES






S. Paragannavar, A. Savadi, B. Pathan, R. Torgalmath, S. Chandaki, S. Rushikesh, Development and Evaluation of Polyherbal Cream for Antiacne, Int. J. of Pharm. Sci., 2026, Vol 4, Issue 3, 735-750. https://doi.org/10.5281/zenodo.18906493
 10.5281/zenodo.18906493
10.5281/zenodo.18906493